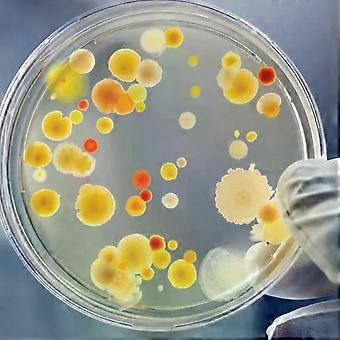
product image

20 Pcs Petri Dish Transparent Culture Dishes Scientific Research Laboratory Mushroom Heavy Duty Biological Plastic Reusable 70mm
+ 9.49 CHF Livraison

20 Pcs Petri Dish Transparent Culture Dishes Scientific Research Laboratory Mushroom Heavy Duty Biological Plastic Reusable 70mm
- Marque: Unbranded
20 Pcs Petri Dish Transparent Culture Dishes Scientific Research Laboratory Mushroom Heavy Duty Biological Plastic Reusable 70mm
- Marque: Unbranded
Économisez 99.05 CHF (83%)
Prix de vente recommandé
Politique de retour sur 14 jours
Économisez 99.05 CHF (83%)
Prix de vente recommandé
Politique de retour sur 14 jours
Modes de paiement:
Description
20 Pcs Petri Dish Transparent Culture Dishes Scientific Research Laboratory Mushroom Heavy Duty Biological Plastic Reusable 70mm
- Marque: Unbranded
- Catégorie: Boîtes de Petri
- Identifiant Fruugo: 415545196-877240293
- EAN: 7283162338669
Informations sur la sécurité des produits
Veuillez consulter les informations de sécurité du produit spécifiques à ce produit décrites ci-dessous.
Les informations suivantes sont fournies par le détaillant tiers indépendant vendant ce produit.
Étiquettes de sécurité des produits

Livraison & retours
Expédition dans un délai de 3 jours
-
EXPRESS: 9.49 CHF - Livraison entre lun. 02 février 2026–mer. 11 février 2026
Expédition de Chine.
Nous mettons tout en œuvre pour que les produits que vous commandez vous soient livrés dans leur intégralité et selon vos indications. Néanmoins, si vous recevez une commande incomplète, des articles différents de ceux commandés ou si, pour toute autre raison, la commande ne vous satisfait pas, vous pouvez retourner la commande ou tout produit inclus dans celle-ci et recevoir un remboursement complet des articles. Voir l'intégralité de la politique de retour
Détails de conformité du produit
Veuillez consulter les informations de conformité spécifiques à ce produit décrites ci-dessous.
Les informations suivantes sont fournies par le détaillant tiers indépendant vendant ce produit.
Fabricant:
Les informations suivantes indiquent les coordonnées du fabricant du produit concerné vendu sur Fruugo.
- UMCU
- shenzhenshixiangpulitiankejiyouxiangongsi
- 301 (308), No. 32, Xiangyin Road, Nanlian Community, Longgang Street, Longgang District
- Shenzhen
- China
- 518000
- teuneva@126.com
- 13535306199
- https://www.fruugo.co.uk/umcu/m-17124?language=en
Personne responsable dans l'UE:
Les informations suivantes indiquent les coordonnées de la personne responsable dans l'UE. La personne responsable est l'opérateur économique désigné basé dans l'UE qui est responsable des obligations de conformité relatives au produit concerné vendu dans l'Union européenne.
- EC REP SERVICES SL
- EC REP SERVICES SL
- Calle Gran Via 49, 7 DCH.
- Madrid
- Spain
- 28013
- ecrepservice@hotmail.com
- 34682797075